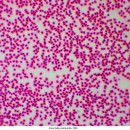

под заказ
от 5 дней
Этой модели пока нет 😥 Но мы подберем вам хороший аналог или привезем под заказ.
Звоните: +375 (29) 557-16-65
Увеличение: 40-1000х
Подсветка: нижняя
Назначение: лабораторный
Лабораторный микроскоп
Цена:
Бесплатно доставим в Минск (выбрать город) (курьером, в течение дня)
Официальная гарантия 2 года! На проверку заводского брака 14 дней
Вы можете забрать этот товар у нас в офисе
(забронировав товар на сайте или по телефону)
г.Минск, пр-т Победителей, 129, оф. 381
Нужна помощь в подборе или совет?
звоните, подскажем
+375 (29) 557-16-65
Delta Optical Genetic Pro Mono (A) - лабораторный монокулярный микроскоп с диапазоном увеличений от 40x до 1000x, оснащенный 4 ахроматическими объективами и конденсором Аббе. Предназначен для лабораторий, а также увлеченных школьников и студентов. При использование дополнительного окуляра 16х (не входящего в комплект) увеличение микроскопа возрастает до 1600х.
Особенности Delta Optical Genetic Pro Mono (A)
- профессиональный лабораторный микроскоп
- револьверное устройство на 4 объектива
- высококачественные ахроматические объективы DIN-стандарта 4x, 10x 40x (S), 100х (S, Oil)
- базовый окуляр Plan 10x (поле зрения 18 мм) позволяет получить увеличения: 40х, 100х, 400х, 1000х
- докупив окуляр 16х возможно повысить увеличение до 1600х
- прочный металлический корпус - ручки тонких движений на предметном столике
- ручки фокусировки грубых и тонких движений
- конденсор Аббе с ирисовой диафрагмой и фильтродержателем
- встроенный аккумулятор
- предназначен для лабораторий, а также для серьёзных домашних исследований школьниками и студентами
В 4-х гнездную револьверную головку микроскопа устанавливаются 4 ахроматических объектива DIN стандарта: 4x, 10x 40x (S), 100х (S, Oil). В комплекте поставляются широкоугольные 10-кратные окуляры с полем зрения 18мм. Возможные увеличение микроскопа в стандартной комплектации: 40х, 100х, 400х, 1000х. Докупив окуляр 16х возможно повысить увеличение до 1600х. Микроскоп имеет стандартную длину тубуса 160мм и поворотную на 360 градусов монокулярную насадку.
Delta Optical Genetic Pro Mono (A) оснащен двухсторонними коаксиальными винтами грубой и точной фокусировки. Оптический микроскоп оборудован предметным столиком 142х132мм, с координатным перемещением в пределах 75х40мм. Под предметным столом расположены коаксиальные винты перемещения столика по оси Х и Y.
Важной частью осветительной системы микроскопа являются конденсор Аббе с ирисовой диафрагмой и фильтродержателем. Конденсор юстируемый по высоте. При желании, конденсор Аббе светлого поля можно сменить на темнопольный конденсор для проведения исследований методом темного поля в проходящем свете, что позволяет наблюдать живые микроорганизмы (коловраток, нематод и др. бактерии), прозрачные или невидимые в светлом поле.
Микроскоп Delta Optical Genetic Pro Mono (A) прекрасно подходит как для обучения (школы, ВУЗы), так и для серьёзных исследований в медицине, биологии и ветеринарии.
Видео-обзор микроскопа Delta Optical Genetic Pro Mono (A)
Что в коробке?
- Микроскоп Delta Optical Genetic Pro Mono (A)
- Окуляр Plan 10x (поле зрения 18 мм)
- Объективы: 4x, 10x 40x (S), 100х (S) (O) (имерсионный)
- Зеленый светофильтр
- Кабель питания 220В
- Иммерсионное масло
- Руководство пользователя и гарантийный талон
Характеристики Delta Optical Genetic Pro Mono (A)
| Общие | |
| Дополнительно | тонкая фокусировка, координатный нониус, подвижный предметный стол, вращаемая насадка, револьверная головка, LED подсветка, микрометрические суппорты |
| Конденсор | конденсор Аббе с ирисовой диафрагмой и фильтродержателем |
| Материал корпуса | металл |
| Метод исследования | светлое поле, темное поле (модицикация), в проходящем свете |
| Объективы | ахроматические 4x, 10x 40x (S), 100х (S) (O) (имерсионный) |
| Окуляры | Plan 10x (поле зрения 18 мм) |
| Подсветка | LED |
| Предметный столик, мм | 142 х 132 |
| Расположение подсветки | нижняя |
| Револьверное устройство | на 4 объектива |
| Регулировка яркости | есть (плавная) |
| Светофильтры | зеленый |
| Тип насадки | монокулярная, поворотная |
| Увеличение, крат | 40х-1000х (с доп. окуляром до 1600х) |
| Материал оптики | оптическое стекло |
| Назначение | биомедицина, фармокология, биология, ботаника, ветеринария, общемедицинские исследования, обучение, пищевая промышленность |
| Оптическая конструкция | |
| оптическая схема | ахромат |
| Потребительские характеристики оптической системы | |
| Фокусер | с рычажками тонкой и грубой фокусировки |
Отзывы о Delta Optical Genetic Pro Mono (A)
Об этом товаре ещё никто не оставлял отзывов.
Будьте первым!